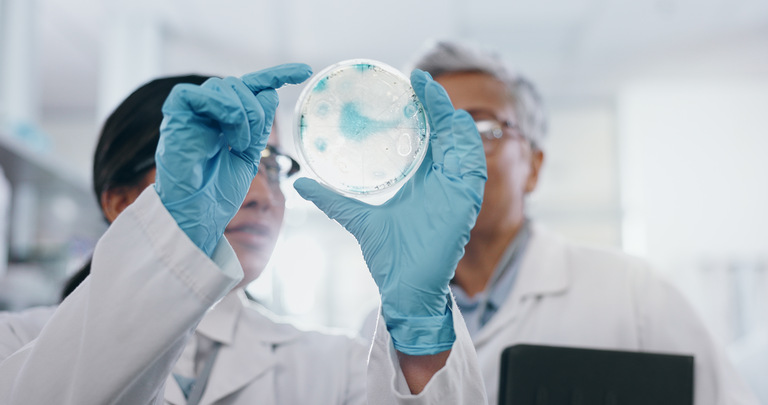

SUSTENTABILIDADE
Fungo entomopatogênico se destaca como alternativa sustentável no combate a pragas
O controle de pragas na agricultura passa por uma transformação impulsionada pela busca por soluções mais sustentáveis e eficazes. As informações são de Marcus Lourenço “Polé”, biólogo, que destaca o avanço do uso de microrganismos no manejo agrícola. Nesse cenário, o fungo entomopatogênico Beauveria bassiana volta a ganhar relevância como alternativa biológica diante do aumento da resistência a Inseticidas químicos.
Presente naturalmente no solo, esse fungo atua de forma silenciosa ao infectar insetos-praga. Ao entrar em contato com o hospedeiro, ele invade o organismo, se desenvolve internamente e leva à morte do inseto, transformando o corpo em um ambiente de multiplicação do próprio fungo. Esse processo o coloca como uma ferramenta estratégica dentro do Manejo Integrado de Pragas.
O uso do Beauveria bassiana já é observado em diferentes culturas, como café, soja, milho, hortaliças e sistemas de cultivo em estufas. Sua aplicação permite reduzir a dependência de químicos, contribuindo para práticas mais alinhadas às exigências ambientais e de mercado. Além disso, sua integração com outras estratégias de manejo amplia a eficiência no controle de populações de pragas.
Apesar das vantagens, ainda existem desafios para ampliar sua adoção em larga escala. Questões relacionadas à eficiência em diferentes condições de campo e à necessidade de aprimoramento tecnológico seguem como pontos de atenção. Ainda assim, o avanço no uso desse fungo indica uma mudança gradual na forma como o controle de pragas é conduzido, com maior protagonismo de soluções biológicas.
Fonte: Agrolink – Leonardo Gottems publicado em 17/04/2026
Fonte da imagem: Freepik



